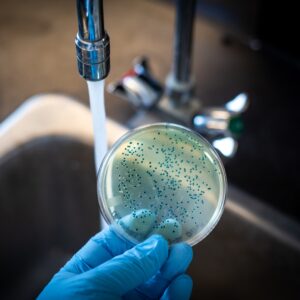
Bakteri Dalam Pipa

KLIN WATER INDONESIA
Ahlinya Pipa Kran Air
Mampet, Kotor dan Berbau
Promo Gratis Cuci Torn / Tandon* Untuk setiap pengambilan paket Detox Pipa Air
KLIN-WATER
99% Rumah Usia Di Atas 5 Tahun Saluran Pipa Air Bersih Perlu Dibersihkan
Pipa air bersih yang tidak dibersihkan secara berkala pada rumah yang usianya di atas 5 tahun dapat menjadi sarang bagi berbagai bakteri, jamur, dan kotoran lainnya yang mengancam kesehatan penghuni rumah. Akumulasi zat-zat tersebut dapat menyebabkan penurunan kualitas air yang digunakan sehari-hari untuk kebutuhan minum, mandi, dan memasak.
Selain itu, kotoran yang menumpuk dalam pipa juga dapat menjadi sumber utama penyakit kulit, gangguan pencernaan, dan masalah kesehatan lainnya. Oleh karena itu, menjaga kebersihan saluran pipa air adalah langkah yang krusial untuk menjaga kesehatan keluarga dan mencegah risiko terjangkitnya penyakit-penyakit yang berpotensi merugikan.
Segera Periksa Keran Air Anda!
Klin Water Indonesia
Dipercaya Ribuan Rumah
Klin Water Indonesia telah dipercaya oleh ribuan rumah untuk menjaga kualitas air bersih mereka. Kami menawarkan solusi handal dan profesional untuk kebutuhan air Anda.
Hingga Hari Ini
Klin Water Telah Mendetoks Bangunan Sebanyak
8724
Rumah, Hotel, Rumah Sakit, Restoran, Ruko, Sekolah, dan Bangunan lainnya
KLIN WATER INDONESIA
Detox Saluran Pipa Air: Solusi Bersihkan Air Keruh dan Berbau Tanpa Membongkar Tembok!
Kualitas air di rumah kita dapat memengaruhi kesehatan keluarga. Masalah serius seperti air keruh, berwarna, dan berbau kurang sedap sering terjadi akibat penampungan air dan saluran pipa yang kotor. Klin Water menawarkan solusi membersihkan saluran pipa tanpa membongkar tembok rumah, menjaga kebersihan air agar keluarga hidup lebih sehat.
Dengan layanan pembersihan Klin Water, detox saluran pipa dapat dilakukan dengan mudah. Kami tidak hanya membersihkan kotoran dan penyumbat, tetapi juga menjaga kejernihan air untuk kesehatan keluarga yang lebih baik. Jangan lewatkan promo menarik Klin Water untuk mendapatkan layanan berkualitas dengan harga terjangkau.
Hubungi Ahli Detox Pipa Air!
KLIN WATER INDONESIA
Layanan & Produk Klin Water
Klin Water Indonesia merupakan penyedia jasa pembersih pipa air lengkap hingga pembersihan toren atau tandon air, serta solusi saluran air mampet dengan berbagai produk dan layanan unggulan.
Jasa Detox Pipa Air
Dengan menggunakan teknologi terkini dan tenaga ahli yang berpengalaman, kami membersihkan pipa-pipa air dari segala jenis kotoran, endapan, dan bakteri yang dapat mengganggu kualitas air minum Anda.
Mesin Pembersih Pipa Air
Mesin pembersih pipa air dengan teknologi canggih yang tidak merusak pipa air. Mesin ini dirancang khusus untuk membersihkan pipa air secara efektif tanpa menyebabkan kerusakan pada struktur atau material pipa.
Keran Air Kecil /
Mampet / Keruh / Bau
Keran air yang kecil, mampet, keruh atau bau bisa menjadi tanda adanya masalah yang lebih dalam pada sistem saluran air Anda.
Cairan Pembersih Pipa Air
Cairan pembersih pipa air food grade yang kami gunakan telah mendapatkan izin resmi dari Kementerian Perindustrian (Kemenperin) dan Badan Pengawas Obat dan Makanan (BPOM).
Jasa Cuci Pipa Kran Mampet
Dengan Jasa Cuci Pipa Kran Mampet Klin Water, Anda dapat mengatasi masalah aliran air yang tersendat atau bahkan mati akibat kotoran dan endapan yang menumpuk di dalam pipa kran.
Tim profesional kami menggunakan teknologi canggih dan cairan pembersih pipa air food grade yang pastinya aman untuk kesehatan, dan tidak hanya membersihkan pipa kran secara menyeluruh, tetapi juga menjaga keamanan sistem pipa air Anda.

Bersihkan Lumpur Dalam Pipa
Dengan teknologi canggih, kami mampu membersihkan lumpur yang terakumulasi di dalam pipa air, memastikan air yang mengalir bersih dan sehat.

Bersihkan Lumut Dalam Pipa Air
Layanan kami secara efektif menghilangkan lumut yang menumpuk di dalam pipa air, menjaga aliran air tetap lancar dan bebas dari kontaminasi organik.

Bersihkan Karat Dalam Pipa Air
Layanan khusus kami dapat mengatasi karat yang terbentuk di dalam pipa air, menjaga kualitas air dan mencegah kerusakan lebih lanjut pada sistem saluran air.
Bersihkan Bakteri Dalam Pipa Air
Kami menggunakan bahan pembersih yang efektif untuk menghilangkan bakteri dan mikroorganisme berbahaya di dalam pipa air, menjaga kebersihan dan kesehatan air yang Anda gunakan sehari-hari.
KLIN WATER INDONESIA
Kami Bangga Dapat Membantu,
Testimoni Pelanggan Tentang Klin Water
God job klin water
Teknisi pak Rizky & pak Taufik sangat profesional.
Recommended..
Blog Pipa Air Bersih
Berbagi informasi terbaru seputar perawatan saluran air, pentingnya menjaga kebersihan toren dan pipa air, serta tips-tips praktis untuk memastikan air yang Anda gunakan di rumah tetap bersih, sehat, dan aman.
Kapan Harus Kuras Toren? Ini Panduan Lengkapnya!
Seberapa Sering Kita Harus Kuras Toren? Pernahkah Anda membuka keran air di rumah atau tempat usaha, lalu merasa airnya berbau aneh, keruh, atau bahkan meninggalkan…
Air Keran Mengecil? Segera Cari Jasa Kran Mampet!
Pernahkah kamu mengalami air keran yang tiba-tiba mengecil, mengalir pelan, atau bahkan tidak keluar sama sekali? Situasi ini sering kali dianggap sepele, padahal bisa menjadi…
Mesin Detox Pipa: Solusi Mudah & Ekonomis Menjadikan Air Anda Lancar Bebas Kotoran
Air bersih merupakan kebutuhan esensial yang harus selalu tersedia untuk kebutuhan di rumah dan bisnis Anda. Namun, pernahkah Anda berpikir tentang saluran pipa yang dilalui…


